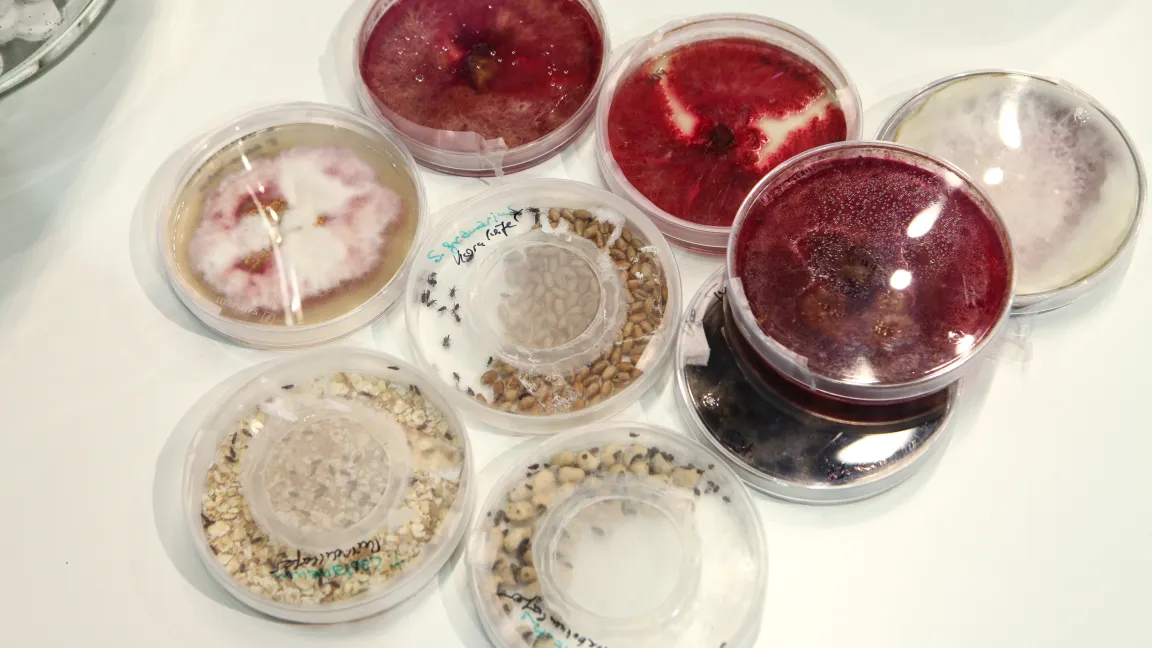

IVA auf der Internationalen Grünen Woche 2016 in Berlin
81. Auflage der weltgrößten Verbraucherschau für Landwirtschaft, Ernährung und Gartenbau am Sonntag in Berlin zu Ende gegangen / knapp 400 000 Besucher
Die Internationale Grüne Woche 2016 in Berlin (15. bis 24. Januar) hat im 90. Jahr ihres Bestehens ihren Stellenwert als Leitmesse und Dialogplattform für das gesamte Agribusiness erneut unterstrichen und verzeichnete eine erfolgreiche 81. Geburtstagsausgabe mit einem leichten Besucherrückgang; knapp 400 000 Besucher (2015: 415 000) kamen in die Messeshallen unter dem Funkturm, darunter über 100 000 Fachbesucher.1660 Aussteller aus 65 Ländern (2015: 1658/68 Länder) beteiligten sich auf einer Ausstellungsfläche von 118 000 Quadratmetern an der weltgrößten Verbraucherschau für Landwirtschaft, Ernährung und Gartenbau.
Der Industrieverband Agrar e. V. (IVA) lud wieder zum Dialog auf die Messe. Am „Treffpunkt Pflanzenschutz und Pflanzenernährung“ im ErlebnisBauernhof in Halle 3.2 stellten sich Experten Fragen zur Agrarchemie und dem Austausch mit den Messebesuchern zu Themen wie Rückständen von Pflanzenschutzmitteln in Lebensmitteln, Nutzen von Pflanzenschutz und Mineraldüngung oder dem Einfluss moderner Landwirtschaft auf die Artenvielfalt.
Partner des Treffpunkts 2016 waren wieder die Junioren der Deutschen Phytomedizinischen Gesellschaft (DPG). Die Nachwuchswissenschaftler gaben einen Einblick in die Arbeit als „Pflanzendoktoren“. Sie erklärten, wie Schädlinge und Pilze unseren Nutzpflanzen zusetzen und welche Medizin der Pflanzenschutz in diesen Fällen bereithält. Ein Publikumsmagnet war der Schreibtisch der DPG-Junioren, an dem man durch ein Stereomikroskop Schädlinge wie Speisebohnenkäfer in 40-facher Vergrößerung bei ihrer verheerenden Arbeit beobachten konnte.